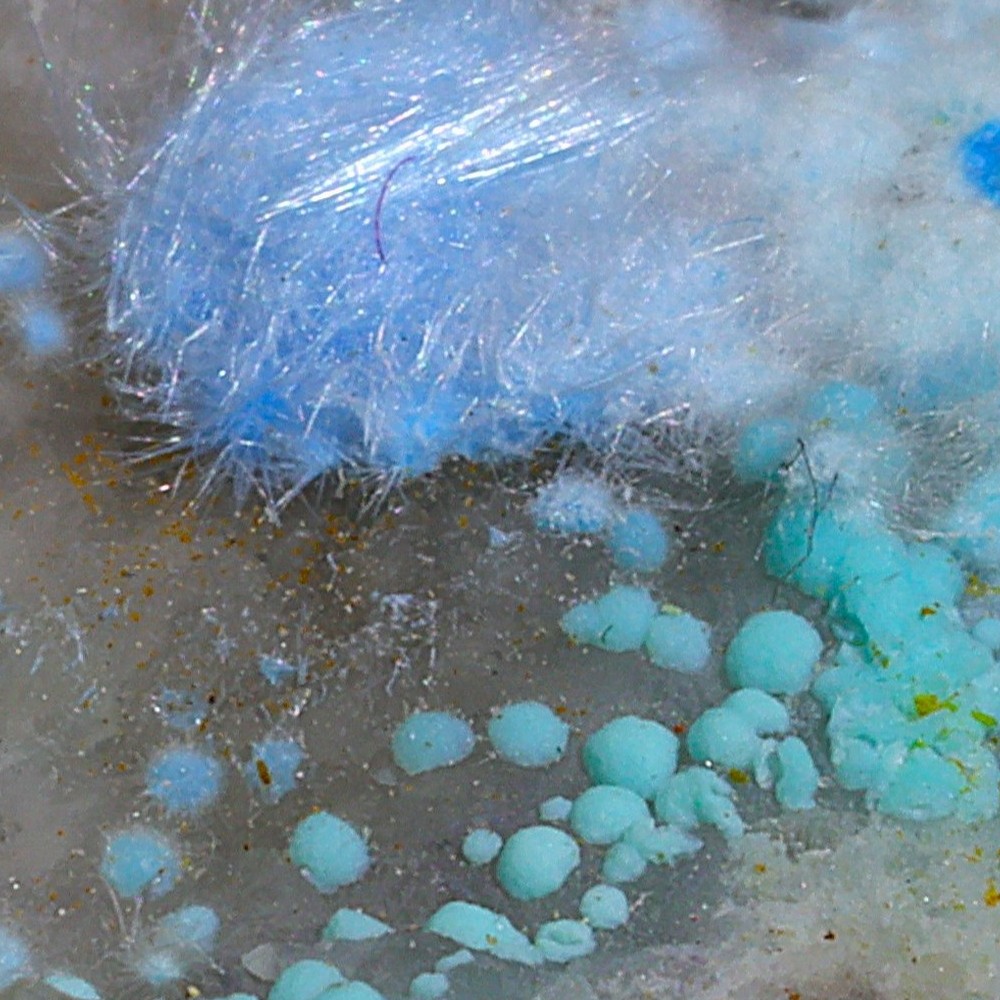

Live & Upcoming Slots
GreekRocks Auction
Ends in 2d 16h 23m
Adrael Minerals
Ends in 5d 16h 23m
Trencapedres Minerals
Ends in 5d 16h 23m
AT Minerals Auction
Ends in 6d 16h 8m
viaMineralia Auction
Starts in 1d 16h 23m
Adrael Minerals Auction
Starts in 5d 16h 38m
Trencapedres Minerals Auction
Starts in 7d 16h 33m
Trencapedres Minerals Auction
Starts in 19d 16h 33m
GreekRocks Auction
Ends in 2d 16h 23m
Adrael Minerals
Ends in 5d 16h 23m
Trencapedres Minerals
Ends in 5d 16h 23m
AT Minerals Auction
Ends in 6d 16h 8m
viaMineralia Auction
Starts in 1d 16h 23m
Adrael Minerals Auction
Starts in 5d 16h 38m
Trencapedres Minerals Auction
Starts in 7d 16h 33m
Trencapedres Minerals Auction
Starts in 19d 16h 33m